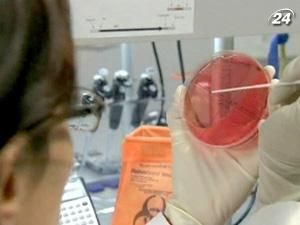
Американські науковці створили штучну клітину Американські науковці створили штучну клітину

Одноклітинним організмом керує штучна ДНК, яку скопіювали з однієї бактерії і помістили в іншу клітину. Синтія уже почала розмножуватися.
Крейг Вентер (мікробіолог): “Ми щойно оголосили про створення клітини, яку повністю контролює штучна хромосома. Її створення розпочалося з генетичного коду на комп’ютері, чотирьох хімікатів і вибудовування понад мільйона комплементарних пар у правильному порядку. Врешті ми помістили цю велику молекулу в іншу клітину”.
Нова технологія може відкрити безмежні можливості перед людством. Фахівці сподіваються, що з часом вони зможуть створити бактерії, які вироблятимуть ліки і пальне, абсорбувати парникові гази і очищати моря від розлитої нафти. Втім, такий задум має і критиків. Вони вважають, що штучні мікроби завдадуть людству значної шкоди. Адже поява на землі нових форм життя може призвести до непередбачуваних наслідків.
Американські науковці створили штучну клітину
Американські науковці зробили перший крок на шляху до створення штучного життя. В лабораторії дослідного інституту у Роквілі фахівці змогли вперше синтезувати штучну клітину. Мікробіолог Крейг Вентер назвав своє творіння Синтією.